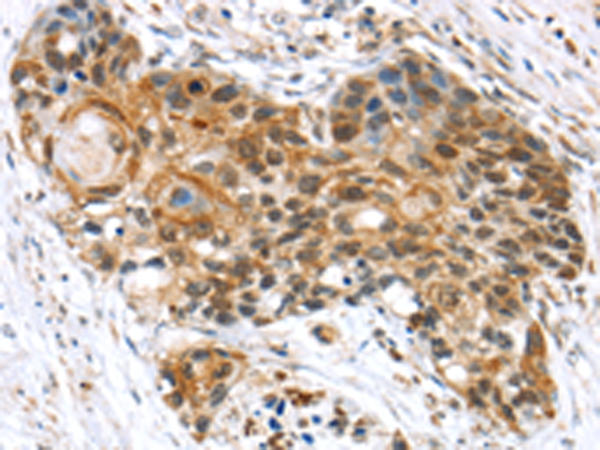

-
分类: 科研抗体货号: P05416别名: LIN41; LIN-41应用: WB反应种属: Human, Mouse, Rat
-
分类: 科研抗体货号: P05364别名:应用: IHC反应种属: Human
-
分类: 科研抗体货号: P05394别名: AS160应用: WB,IHC反应种属: Human, Mouse
-
分类: 科研抗体货号: P05414别名: HLS5; MAIR应用: WB,IHC反应种属: Human
-
分类: 科研抗体货号: P05363别名: CT5.4应用: IHC反应种属: Human
-
分类: 科研抗体货号: P05392别名: APT2; PSF2; ABC18; ABCB3; PSF-2; RING11; D6S217E应用: IHC反应种属: Human, Mouse, Rat
-
分类: 科研抗体货号: P05411别名: RNF94; STAF50; GPSTAF50应用: WB反应种属: Human
-
分类: 科研抗体货号: P05362别名: SSX; HD21; CT5.2; CT5.2A; HOM-MEL-40应用: IHC反应种属: Human
-
分类: 科研抗体货号: P05390别名: TAF2A; TAF2H; TAFII30应用: WB,IHC反应种属: Human, Mouse
-
分类: 科研抗体货号: P05398别名: SIII; TCEB3; TCEB3A; SIII p110应用: IHC反应种属: Human

鄂公网安备42018502007531号
鄂公网安备42018502007531号

